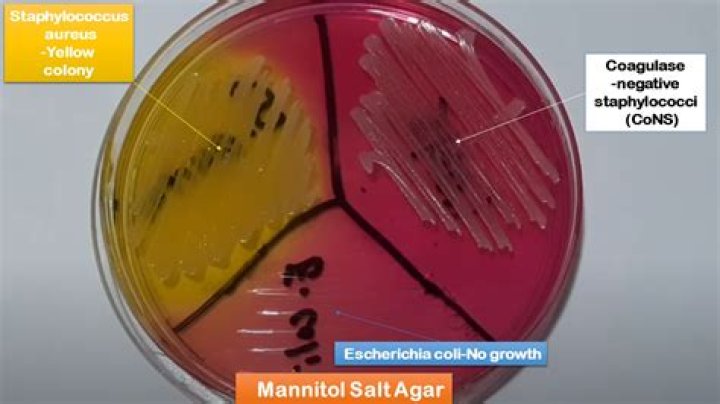
Does Bacillus cereus grown on mannitol salt agar

The large colonies at the center of the plate are Bacillus cereus. Although these organisms grow well on nutrient agar, they are not halophiles so will not grow on mannitol salt agar.
Is Bacillus cereus mannitol positive?
B. cereus colonies are usually lecithinase-positive and mannitol-negative on MYP agar.
What bacteria grows on mannitol salt agar?
Staphylococcus aureus and Staphylococcus epidermidis on mannitol salt agar. Mannitol salt agar is a commonly used growth medium in microbiology. It encourages the growth of a group of certain bacteria while inhibiting the growth of others.
Can Bacillus cereus ferment mannitol?
cereus. From the metabolic point of view it has catalase, reduces nitrates to nitrites, gives the Voges Proskauer reaction, ferments glucose, sucrose, salicin and glycerol, does not ferment mannitol, nor arabinose and produces lecithinase.What bacteria Cannot Grow on mannitol salt agar?
Most pathogenic staphylococci, such as Staphylococcus aureus, will ferment mannitol. Most non-pathogenic staphylococci will not ferment mannitol. The Staphylococcus aureus ferments mannitol and turns the medium yellow. The Serratia marcescens does not grow because of the high salt content.
Does Bacillus cereus produce mannitol acid?
B. cereus is differentiated from other members of the Bacillus group by two reactions: mannitol fermentation and lecithinase production. Mannitol fermentation on this medium produces a yellow color, due to the indicator dye, phenol red changing color as acid is produced.
How do you grow Bacillus cereus?
cereus grows best in a temperature range of 39ºF (4ºC) to 118ºF (48ºC). Optimal growth occurs within the narrower temperature range of 82ºF (28ºC) to 95ºF (35ºC) and a pH range of 4.9 to 9.3 (FDA 2012b). While there are numerous known species in the genus Bacillus, only two, B. anthracis and B.
Can Bacillus cereus ferment?
Cereus is motile, catalase positive, able to ferment glucose, unable to ferment lactose, able to reduce nitrate to non gaseous nitrogenous compounds, produces amylase, and has alpha hemolytic activity.Does Bacillus megaterium ferment mannitol?
The medium contains peptic digest of animal tissues and meat extract, which provide nitrogenous compounds. Mannitol serves as the fermentable carbohydrate, fermentation of which can be detected by phenol red. Mannitol fermenting organisms like B. megaterium yield yellow coloured colonies as shown in Figure 4.
What stain is used for Bacillus cereus?The use of the lipid globule stain to aid in differentiating the Bacillus cereus group (i.e., B.
Article first time published onWhy doesn't e coli grow on mannitol salt agar?
Gram-negative bacteria like E. coli and P. aeriginosa are not tolerant to salt (not halophilic) and will not grow colonies on MSA (see quadrants II and IV). … Staphylococcus aureus is also able to ferment mannitol, because this bacterial species has the enzyme coagulase required for the process.
Can Gram positive bacteria grow on mannitol salt agar?
It contains a high concentration (about 7.5–10%) of salt (NaCl) which is inhibitory to most bacteria – making MSA selective against most Gram-negative and selective for some Gram-positive bacteria (Staphylococcus, Enterococcus and Micrococcaceae) that tolerate high salt concentrations.
Can Streptococcus grow on mannitol salt agar?
Both streptococcal organisms are catalase negative and beta-hemolytic on sheep blood agar plates. Also, neither would grow on the mannitol salt agar. Streptococcus pyogenes is sensitive to growth inhibition by bacitracin, whereas Streptococcus agalactiae (group B streptococci) is not.
What are the roles of mannitol and salt in the mannitol salt agar?
MSA inhibits all gram-negative cells which leave gram-positive cells. The sodium chloride in MSA ensures that only Staphylococci species survive due to the high salt concentration. This eliminates all other gram-positive microbes.
Does Enterobacter aerogenes Grow on mannitol salt agar?
This test showed the bacterium did not contain the enzyme urease. Four more tests, Casein, Starch, Simmons Citrate and a Nitrate test, were all performed to confirm the bacterium was Enterobacter aerogenes. … This resulted in the growth of bacteria and the MSA test was concluded to be positive for mannitol fermenters.
How EMB media differentiate bacteria?
Differentiation of enteric bacteria is possible due to the presence of the sugars lactose and sucrose in the EMB agar and the ability of certain bacteria to ferment the lactose in the medium. … This metallic green sheen is an indicator of vigorous lactose and/or sucrose fermentation ability typical of fecal coliforms.
Does Bacillus subtilis ferment mannitol?
Bacillus subtilis is not able to ferment mannitol and yet the Mannitol test yielded a positive result.
What does Bacillus cereus need to grow?
cereus grows in a range of 10 to 50 °C, with a temperature optimum between 30 and 40 °C. However, individual cold-tolerant strains can also multiply at temperatures of 4 to 6 °C, though with considerably longer generation times. In dry or acidic foods B. cereus is not able to grow.
Does Bacillus cereus grown on MacConkey Agar?
Bacillus cereus has a large, smooth, pink colonies with mousy smell on MacConkey’s agar. Lactose non-fermenter colonies on the MacConkey’s agar and central black, small size colonies with smooth to rough in appearance on the Salmonella-Shigella agar were identified as Salmonella spp.
What is Bacillus cereus selective agar?
Bacillus cereus Selective Agar is based on the highly specific diagnostic and selective PEMBA medium, developed by Holbrook and Anderson1 for the isolation and enumeration of Bacillus cereus in foods. … These features distinguish Bacillus cereus from other Bacillus spp. except Bacillus thuringiensis.
Is Bacillus cereus aerobic or anaerobic?
Bacillus cereus is a facultative anaerobic microorganism, i.e., it can survive at various levels of oxygenation.
What is the morphology of Bacillus cereus?
Morphology of Bacillus cereus Bacillus cereus is gram-positive rod-shaped bacilli with square ends. Occasionally may appear gram variable or even gram-negative with age. They are single rod-shaped or appear in short chains. Clear cut junctions between the members of chains are easily visible.
Does Bacillus megaterium grow on blood agar?
This photograph depicts the colonial morphology displayed by Gram-positive, Bacillus megaterium bacteria, which was grown on a medium of sheep’s blood agar (SBA), for a 24-hour time period, at a temperature of 37°C. The overall colonial morphology displayed by B. megaterium is very similar to that displayed by B.
Does Bacillus megaterium form endospores?
Bacillus megaterium is a gram positive, endospore forming, rod shaped bacteria. It is considered aerobic.
How can you tell the difference between Bacillus species?
Bacillus anthracis and Bacillus cereus can usually be distinguished by standard microbiological methods (e.g., motility, hemolysis, penicillin susceptibility and susceptibility to gamma phage) and PCR.
Is Bacillus cereus lactose fermenting?
cereus isolates are unable to ferment lactose, they can grow in milk products upon hydrolysis of milk proteins or by glucose consumption following the fermentation of lactose by competitive microorganisms, for example lactic acid bacteria.
Is Bacillus cereus salt tolerance?
The maximum salt concentration tolerated by B. cereus for growth is reported to be 7.5% (Rajkowski and Bennett 2003). B. cereus growth is optimal in the presence of oxygen, but can occur under anaerobic conditions.
Does Bacillus cereus hydrolyze starch?
cereus has been reported to neither produce diarrheal toxin nor hydrolyze starch (Ehling-Schulz et al., 2005; Pirhonen et al., 2005). Besides the enterotoxins and emetic toxin, B. cereus produces several other virulence factors that damage the cell membrane.
What color does Bacillus cereus stain?
Gram-positive bacteria retain the color of the primary stain (crystal violet) in the Gram staining procedure and appear as purple/violet under a light microscope. These bacteria have a cell wall containing a thick layer of peptidoglycan.
How do you identify Bacillus cereus?
Basic CharacteristicsProperties (Bacillus cereus)Gelatin HydrolysisNegative (-ve)Gram StainingPositive (+ve)Growth in KCNPositive (+ve)HemolysisPositive (+ve)
How is Bacillus cereus identified?
The traditional method of B. cereus detection is based on the bacterial culturing onto selective agars and cells enumeration. In addition, molecular and chemical methods are proposed for toxin gene profiling, toxin quantification and strain screening for defined virulence factors.